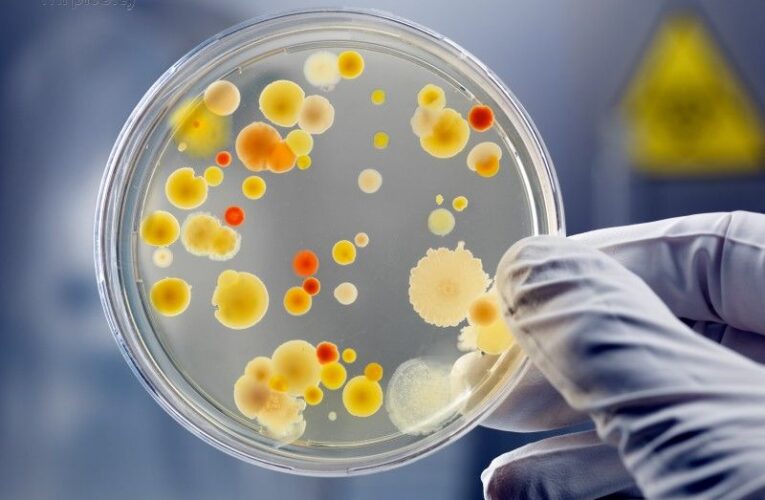
Пять штаммов гриппа ожидается в Украине этой зимой

Український бізнес в реєстрах РФ: пов’язані з Владиславом Гельзіним структури можуть працювати в окупованному Криму
Чому театр ляльок – не лише для дітей
Криваві ягоди: як полтавські чиновники та бізнес заробили 7,6 міліона на дронах для військових
Олена Семеняка висловлює подяку LDK Palikuonys за незмінну підтримку України
Заступник голови Державного агентства відновлення України Сергій Сверба купує квартири та віддає борги в кріптовалюті
ДБР оголосило підозру у розтраті майже 5 млн грн генеральному директору «Нижньодністровської ГЕС»
Чому українська ковбаса дорожча за італійську і як «відкатні» схеми «УкрХімТеху» нищать бізнес
Коли «фармацевтика» дорожча за совість
ЄС найближчим часом зосередиться на поставках зброї Україні
Наступні кілька тижнів визначатимуть, чи буде Україна надалі існувати – The Washington Post